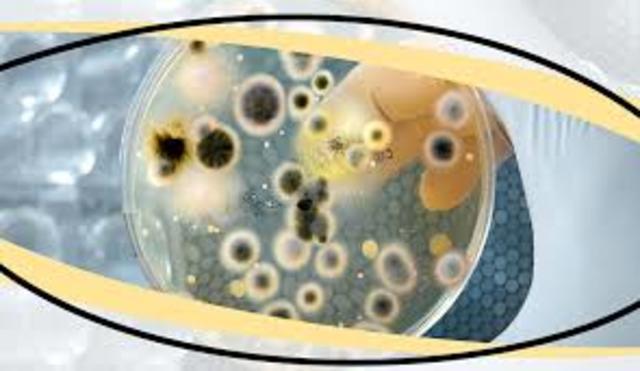
Discovery of Bacterial Origin of Fermentation

-
Yogurt and cheese made with lactic acid-producing bacteria by various cultures
-
Antonie Van Leeuwenhoek discovers and describes bacteria and protozoa
-
Edward Jenner uses first viral vaccine to inoculate a child from smallpox
-
Louis Pasteur discovered the bacterial origin of fermentation
-
Gregor Mendel discovers the laws of inheritance
-
Robert Koch develops a technique for staining bacteria for identification
-
Louis Pasteur develops vaccines against bacteria that cause cholera and anthrax in chickens
-
Louis Pasteur and Emile Roux developed the first rabies vaccine and use it on Joseph Meister
-
Karl Ereky, a Hungarian agricultural engineer, first uses the world biotechnology.
-
Alexander Fleming notices that a certain mold could stop the duplication of bacteria. Leading to the first antibiotic:penicillin
-
James D. Watson and Francis Crick describe the structure of DNA
-
The DNA composition of chimpanzees and gorillas is discovered to be 99% similar to that of humans
-
Stanley Norman Cohen and Herbert Boyer perform the first successful recombinant DNA experiment, using bacterial genes
-
The U.S. patent for gene cloning is awarded to Cohen and Boyer
-
Scientists in Switzerland clone mice. The first transgenic animals are produced by transferring genes from other animals into mice.
-
Humulin, Genentech’s human insulin drug produced by genetically engineered bacteria for the treatment of diabetes, is the first biotech drug to be approved by the Food and Drug Administration
-
The Polymerase Chain Reaction(PCR) technique is formulated by Kary B. Mullis
-
The first federally approved gene therapy treatment is performed successfully by William French Anderson, on a young girl who suffered from an immune disorder.
-
The United States Food and Drug Administration approved the first DM food: “Flavr Savr” tomato, invented by Monsanto
-
The first vaccine for hepatitis A is developed. The NIH, the U.S. Army and the Centers for Disease Control and Prevention are significantly involved in the development and clinical testing of the vaccine.
-
The Department of Biochemistry at Stanford University and Affymetrix develop the GeneChip, a small glass or silica microchip that contains thousands of individual genes that can be analyzed simultaneously.
-
British scientists, led by Ian Wilmut from the Roslin Institute, report cloning Dolly the sheep using DNA from two adult sheep cells.
-
The first human artificial chromosome is created. A combination of natural and synthetic DNA is used to create a genetic cassette that can potentially be customized and used in gene therapy.
-
In Japan, two research teams culture embryonic stem cells, which are used to regenerate tissue. From there the teams and the lead scientist Dr Takashi Tsuji, cultivated human skin.
-
Completion of a “rough draft” of the human genome in the Human Genome Project led by Francis Sellers Collins
-
Rice becomes the first crop to have its genome decoded. This experiment was conducted by various scientists from Japan, Korea, China, the United Kingdom, and the United States
-
The Department of Energy (DOE) and their partners in the International Human Genome Sequencing Consortium announced that The Human Genome project is completed, providing information on the locations and sequence of human genes on all 46 chromosomes.
-
The first Nanoradio is described by Alex Zettl
-
Japanese astronomers launched the first Medical Experiment Module called “Kibo”, to be used on the International Space Station
-
Cedars-Sinai Heart Institute uses modified SAAN heart genes to create the first viral pacemaker in guinea pigs, now known as iSANs
-
U.S. President Barack Obama signs executive order freeing up federal funding for broader research on embryonic stem cells. Researchers identify three new genes associated with Alzheimer's disease. Geron initiates the first FDA approved clinical trial using embryonic stem cells.
-
FDA approves the first cord blood therapy to be used in hematopoietic stem cell transplantation procedures in patients with disorders affecting the hematopoietic (blood forming) system.
-